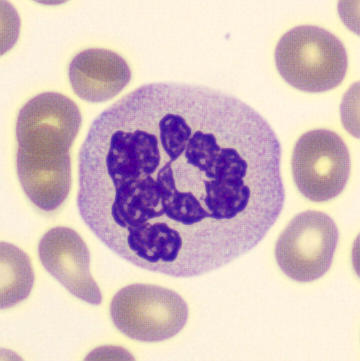
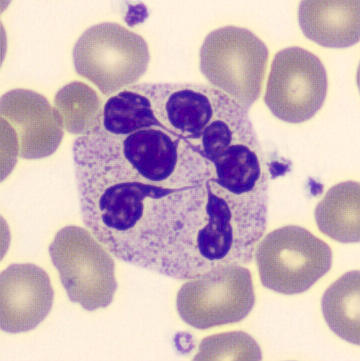
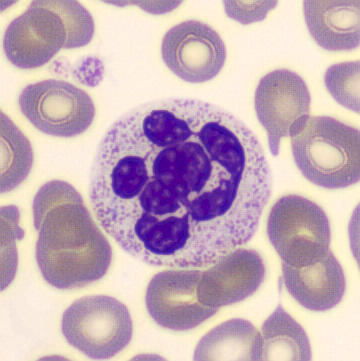
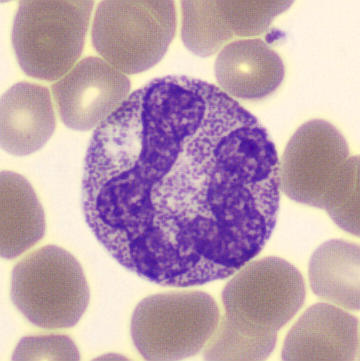
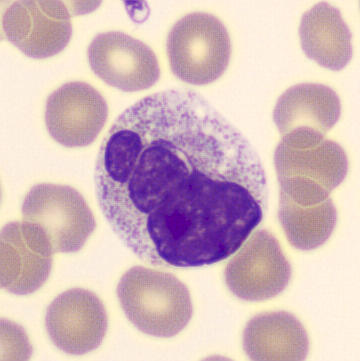
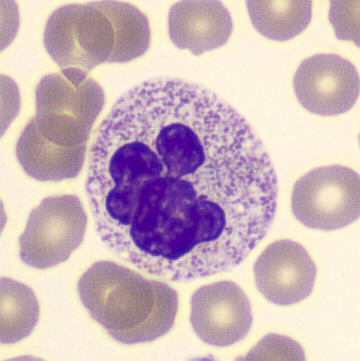
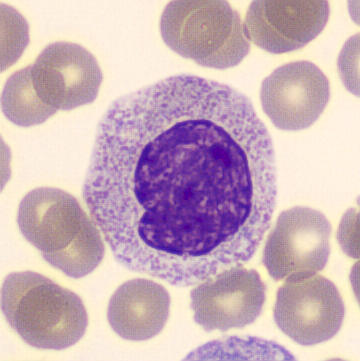
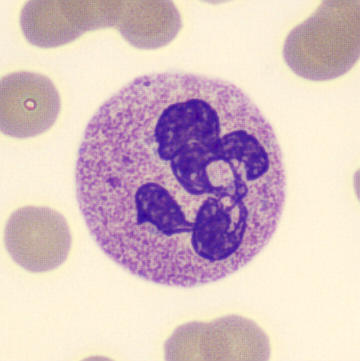

Macropolycyte
Synonyms: Giant forms, Giant neutrophils
A macropolycyte is a highly enlarged neutrophil with that can have either a hyper-segmented nucleus or a hypo-segmented nucleus.
Strong hypersegmentation occurs when chromosomes are present in the cell not twice, but four times (tetraploidy). Macropolycytes with hypersegmentation are classically seen in vitamin B12 deficiency. However, this abnormality can also occur in deranged myelopoiesis, for example due to MDS, hematologic neoplasias, G-CSF therapy, sepsis or chemotherapy. In particular, such causes should be considered in the case of hyposegmentation or nuclear forms other than hypersegmentation.
Hypersegmentation

hyposegmentation